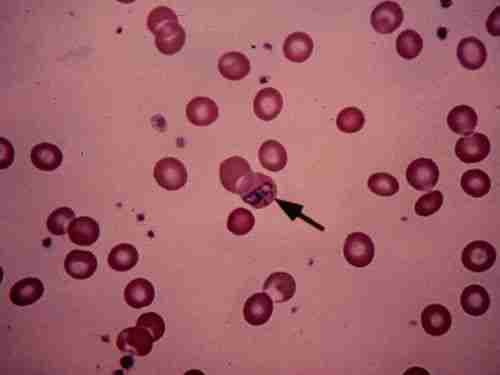

A Candida tünetei, kimutatása és kezelése röviden


Amit eszel, azzá leszel: a candida

A fertőzéses íny- és szájgyulladások

Amikor ott viszket, ahol nem kéne – a nemi szervek gombás fertőzései

Grapefruittal a Candida tünetei ellen





Candida albicans – élesztő szindróma